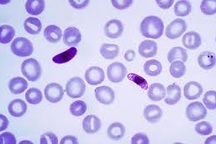
Chế tạo thành công 4 loại test phát hiện ký sinh trùng sốt rét

Phát hiện 5 ca sốt rét, giám sát các trường hợp sốt đến viện
(Dân trí) - Sở Y tế TPHCM yêu cầu tất cả các cơ sở khám chữa bệnh khi tiếp nhận một trường hợp có sốt và đi từ các vùng có sốt rét lưu hành về cần nghĩ ngay đến bệnh sốt rét.
Ngày 10/6, Sở Y tế TPHCM cho biết, trong tuần lễ cuối tháng 5 năm 2022, Bệnh viện Bệnh Nhiệt đới (BVBNĐ) đã tiếp nhận điều trị 2 trường hợp sốt rét ác tính nhập cảnh từ châu Phi.
6 tháng đầu năm có 5 ca sốt rét
Trường hợp đầu tiên là một nữ du học sinh 24 tuổi, nhà ở quận Bình Thạnh, đang học tại Cameroon khoảng 10 tháng qua. Sau khi về nước, bệnh nhân có kết quả test nhanh dương tính với ký sinh trùng gây sốt rét ngày 24/5, được chẩn đoán sốt rét ác tính thể não, vàng da và mật độ ký sinh trùng cao. Sau 6 ngày điều trị tích cực, bệnh nhân được xuất viện.
Trường hợp thứ 2 là người đàn ông 63 tuổi, người Trung Quốc. Ngày 31/5, bệnh nhân từ Bờ Biển Ngà về Việt Nam bằng máy bay, có quá cảnh 10 giờ ở Thổ Nhĩ Kỳ. Bệnh nhân lên cơn sốt lạnh run trên chuyến bay về Việt Nam. Khi về TPHCM, bệnh nhân được chẩn đoán sốt rét ác tính thể vàng da, suy thận, nhiễm toan, hiện vẫn đang được điều trị hồi sức tích cực.

Bệnh viện Bệnh Nhiệt đới TPHCM (Ảnh: Hoàng Lê).
Theo báo cáo từ BVBNĐ, năm 2020 nơi này tiếp nhận điều trị 5 trường hợp sốt rét. Đến năm 2021 chỉ có 2 trường hợp, không có tử vong. Trong 6 tháng đầu năm 2022, bệnh viện ghi nhận 5 trường hợp sốt rét, trong đó có 2 trường hợp sốt rét ác tính. Tất cả các bệnh nhân sốt rét nhập viện và điều trị trong các năm qua là những trường hợp đi công tác tại vùng có sốt rét lưu hành, như Tây Nguyên, châu Phi...
Cần khai thác tiền sử đi lại của bệnh nhân sốt
Trên bình diện Việt Nam, bệnh sốt rét lưu hành quanh năm tại các tỉnh rừng núi miền Bắc, miền Trung, Tây Nguyên và Đông Nam Bộ. Trong đó, số ca bệnh sốt rét gia tăng trong mùa mưa. Theo báo cáo của Bộ Y Tế, trong năm 2021 cả nước có 465 bệnh nhân sốt rét, giảm 67% so với năm 2020, không có ca tử vong. Tại khu vực phía Nam, ghi nhận 43 ca sốt rét, giảm 76% so với năm 2020.
Đến hết năm 2021 cả nước đã có 36 tỉnh thành được công nhận loại trừ bệnh sốt rét. Theo kế hoạch, Việt Nam đang phấn đấu để đạt loại trừ sốt rét vào năm 2030.

Sở Y tế TPHCM yêu cầu tất cả các cơ sở khám chữa bệnh cần chú ý khai thác yếu tố tiền sử đi lại của bệnh nhân có sốt (Ảnh minh họa: Hoàng Lê).
Tại TPHCM, từ năm 2011 đến nay không phát hiện ca bệnh sốt rét nội tại (mắc bệnh tại TPHCM) mà tất cả đều là các ca nhiễm từ các vùng dịch tễ lưu hành. TPHCM đã được công nhận loại trừ sốt rét từ năm 2020, hiện nay đang trong giai đoạn phòng ngừa sốt rét quay trở lại.
Vì TPHCM là nơi có biến động dân cư rất lớn và cũng là nơi tập trung nhiều bệnh viện tuyến cuối, nên hàng năm vẫn ghi nhận một số trường hợp sốt rét là những người đến từ vùng đang có dịch sốt rét lưu hành. Ngành y tế khuyến cáo người dân chủ động thực hiện các biện pháp tiêu diệt lăng quăng, ngăn ngừa muỗi đốt để phòng tránh các bệnh lây lan do muỗi truyền.
Về mặt chẩn đoán và điều trị, Sở Y tế TPHCM yêu cầu tất cả các cơ sở khám chữa bệnh khi tiếp nhận một trường hợp có sốt cần chú ý khai thác yếu tố tiền sử đi lại của bệnh nhân.
Khi bệnh nhân đi từ các vùng có sốt rét lưu hành về thì cần nghĩ ngay đến bệnh sốt rét và tiến hành xét nghiệm tìm ký sinh trùng sốt rét để kịp thời điều trị, ngăn ngừa biến chứng nặng và tử vong.
Ngành y tế TPHCM cho biết, sốt rét là bệnh truyền nhiễm gây ra bởi ký sinh trùng Plasmodium, lây truyền từ người bệnh sang người lành khi bị muỗi đốt. Muỗi Anopheles là trung gian truyền bệnh sốt rét. Ký sinh trùng sốt rét không tồn tại ở ngoại cảnh, chỉ tồn tại trong máu người bệnh và trong cơ thể muỗi truyền bệnh sau khi chích người bệnh. Do đó điều kiện để lây truyền bệnh sốt rét là phải có muỗi Anopheles và có người đang bị bệnh.
Bệnh sốt rét nếu không được chẩn đoán và điều trị kịp thời sẽ xuất hiện các biến chứng nặng - thể sốt rét ác tính (như biến chứng não gây hôn mê sâu, co giật, suy gan, suy thận, thiếu máu nặng, tiểu huyết cầu tố do vỡ hồng cầu hàng loạt...), khi đó nguy cơ tử vong là rất cao.
Những người chưa từng bị sốt rét (chưa có miễn dịch) là nhóm có nguy cơ cao xuất hiện các biến chứng nặng và tử vong khi nhiễm ký sinh trùng. Nhóm này cần được phát hiện sớm, điều trị đúng và kịp thời.